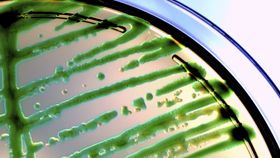
article image

Aminoglycosides are an effective class of antibiotics that are commonly given to combat aerobic, gram-negative bacteria that can create life-threatening infections, such as tuberculosis, septicemia, and pneumonia. Though these drugs are widely prescribed around the globe as a means to save lives, they come with a very high risk of ototoxicity. That is, they carry up to a 60% chance of damaging the patient’s hearing, and kidney damage is an additional threat. A slight modification has allowed the antibiotic to remain effective against infections, while significantly reducing hearing and kidney damage in mice. Alan Cheng and Anthony Ricci from Stanford University School of Medicine were co-senior authors of the study, published in the Journal of Clinical Investigation.
The rest of this article is behind a paywall. Please sign in or subscribe to access the full content.The hearing loss occurs as collateral damage from the antibiotic’s function. These drugs work by interrupting protein synthesis in the bacteria, preventing it from replicating. Unfortunately, the hair cells of the inner ear are often damaged by the potent medication, resulting in hearing loss ranging from tinnitus to total deafness. Because the hair cells are unable to regenerate, the hearing loss is irreversible. Though the drugs may not be perfect, they are still used because the benefit of saving a life is worth the risk of losing hearing. Diminishing that risk would make the product much more desirable.
"If we can eventually prevent people from going deaf from taking these antibiotics, in my mind, we will have been successful,” Ricci said in a press release. "Our goal is to replace the existing aminoglycosides with ones that aren't toxic.”
Cheng and Ricci teamed up in 2007 to explore ways of preventing damage from aminoglycosides. Instead of using a second drug to protect cells in the inner ear and kidney, they found a way to modify the antibiotic itself so that it is not even able to enter the ion channel of those cells. This was important, because while it protects the human cells, it does not inhibit the antibiotic’s function when it is fighting the infection.
"We figured, well, let's not mess with that part of the drug," Ricci continued. "We targeted sites on the drug molecule that were not involved in the antimicrobial activity that kills off infection. This allowed us to reduce toxicity to the ear while retaining antimicrobial action."
After several years of drug development, the team was able to create nine compounds that are functionally similar to the aminoglycoside sisomicin. The most effective modified version, dubbed N1MS, was able to fight off urinary tract infections in mice as effectively as the traditional drug, without causing kidney or hearing damage.
Aminoglycosides are popular around the globe because they are very effective, inexpensive, and do not need to be refrigerated. However, the inherent risk of deleterious side effects causes some physicians to think twice before prescribing them, though some doctors working in rural, developing areas or those dealing with severely immunocompromised patients are not fortunate enough to have much of a choice. The researchers hope to bring N1MS to human clinical trials soon, as it could have profound implications for patients who have received aminoglycosides.
"As a clinician-scientist, I treat kids with hearing loss," Cheng added. "When a drug causes hearing loss it is devastating, and it's especially disturbing when this happens to a young child as they rely on hearing to acquire speech.”